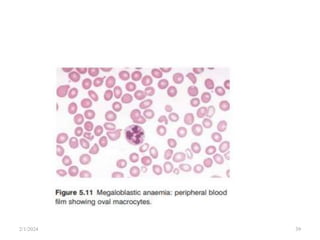
2/1/2024 39

This document discusses megaloblastic anemia, specifically focusing on vitamin B12 and folate deficiencies. It defines megaloblastic anemia and describes the mechanisms, causes, metabolism, functions, and pathophysiology of vitamin B12 and folate. It also discusses pernicious anemia, masked megaloblastic anemia, and provides diagrams of vitamin B12 absorption, transport, and biochemical functions. The key points covered are the roles of vitamin B12 and folate in DNA synthesis, the resulting impaired cell proliferation and megaloblast formation in bone marrow, and the clinical effects of ineffective hematopoiesis.